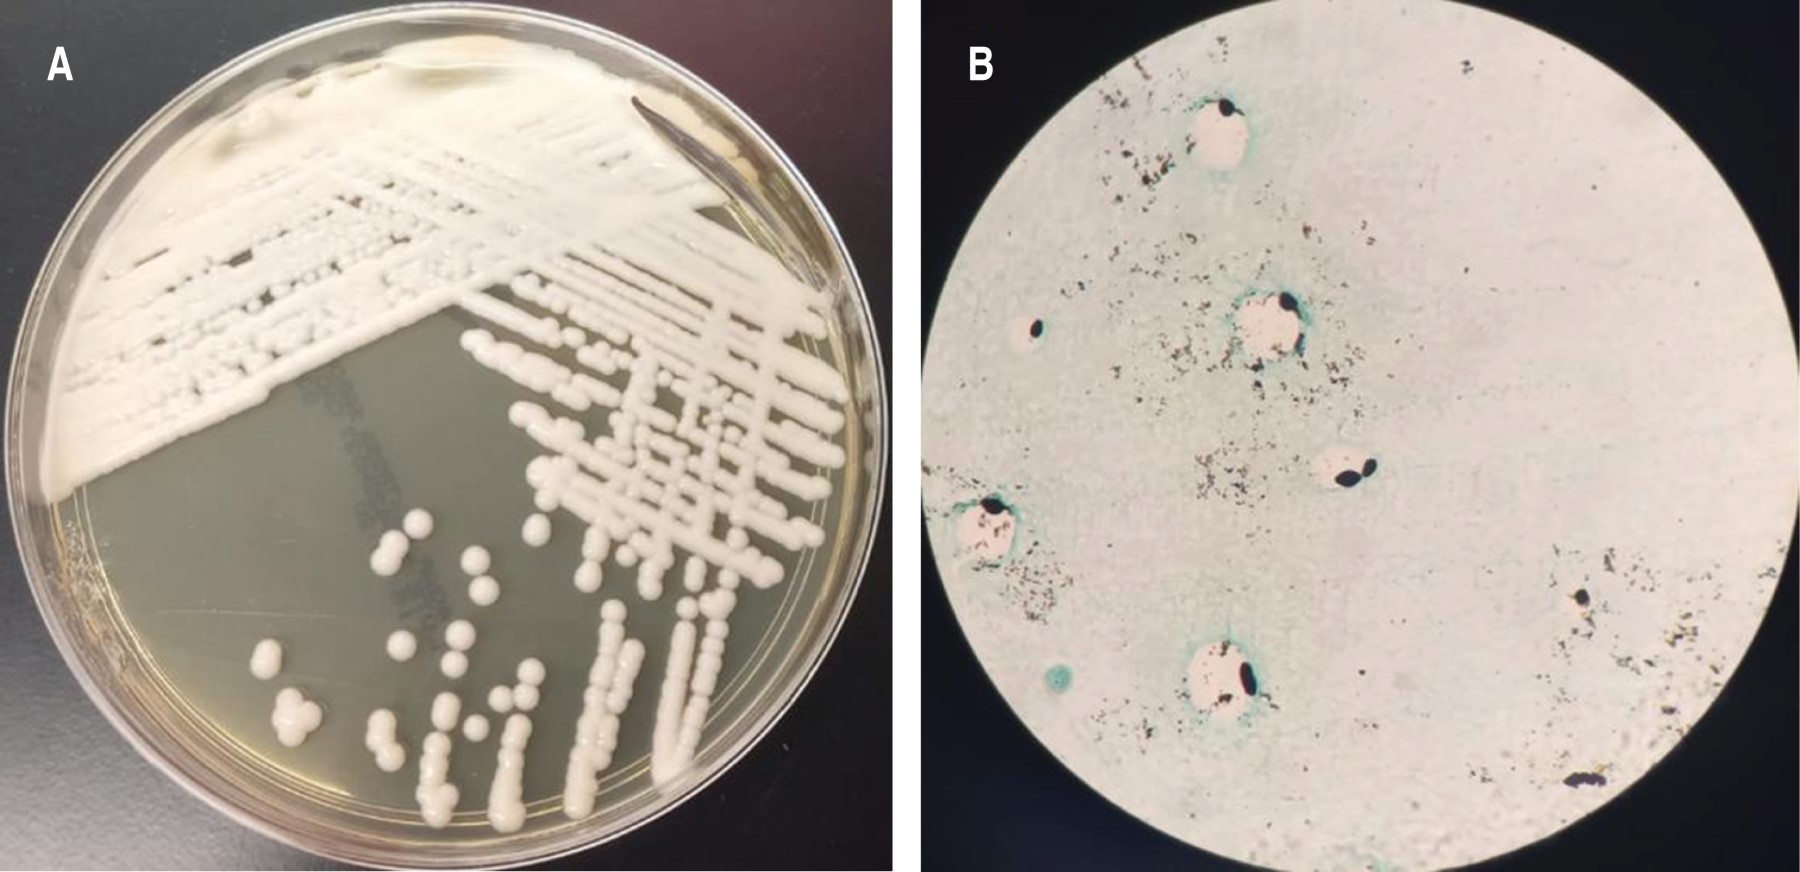

Criptococosis diseminada en un paciente inmunocompetente: reporte de un caso y revisión de la literatura
Cano-Sánchez, Néstor Emmanuel1; Cárcamo-Urízar, María Alejandra1
Cano-Sánchez, Néstor Emmanuel1; Cárcamo-Urízar, María Alejandra1
RESUMEN
La criptococosis es una enfermedad que se produce por la infección de levaduras encapsuladas de las especies Cryptococcus sp., principalmente C. neoformans y con menor frecuencia C. gattii; se considera una infección oportunista debido a su mayor afección en pacientes con factores de riesgo. La transmisión ocurre principalmente por medio de las esporas o células desecadas del hongo que se encuentran presentes en el ambiente y penetran por vía respiratoria al interior del organismo; rara vez se produce por inoculación accidental o por la penetración a través de heridas o lesiones. Reportamos el caso de un varón de 52 años, sin inmunocompromiso conocido (virus de la inmunodeficiencia humana, diabetes mellitus tipo 2, cáncer o trasplante) con criptococosis diseminada; con cuadro clínico de dos años de evolución con tos y expectoración, hemoptoicos, pérdida ponderal, cefalea y pérdida del estado de alerta. Se hospitalizó para estudios de extensión concluyendo en criptococosis diseminada.PALABRAS CLAVE
criptococosis, criptococosis diseminada, Cryptococcus gattii, inmunocompetente.Introducción
La criptococosis es una infección fúngica causada principalmente por Cryptococcus neoformans y gattii,1 comúnmente se asocia con un sistema inmune comprometido. Una infección diseminada en un paciente inmunocompetente es extremadamente raro.2
Se presenta el caso de un paciente mexicano de 52 años de edad a quien se documentó criptococosis pulmonar y, posteriormente, en cerebro, linfadenopatía mediastinal y pericardio.
Presentación del caso
Masculino de 52 años, residente de Chimalhuacán, Estado de México, de ocupación albañil, antecedente de visita a cuevas en Veracruz; sin enfermedades crónico-degenerativas, cáncer, empleo de fármacos, niega tabaquismo y etilismo. Inició dos años previos, con tos con expectoración amarillenta, hemoptoicos ocasionales sin repercusión hemodinámica o respiratoria; pérdida ponderal de 22 kilos en seis meses, astenia, adinamia, disfagia a sólidos, así como cefalea holocraneana de forma constante sin identificar atenuantes ni exacerbantes. Con pérdida del estado de alerta 20 días antes a su ingreso, acudió con médico quien solicitó estudio tomográfico en el que se observa conglomerado ganglionar a nivel de 4R paratraqueal y 7 subcarinal, a nivel de mediastino medio se observó imagen heterogénea de 4.7 × 4.8 cm con 75 UH y realce al medio de contraste, compresión extrínseca del esófago y patrón de llenado alveolar en lóbulo medio asociado a nódulos sólidos y semisólidos espiculados (Figura 1).
Por consulta externa se realizó broncoscopia con hallazgos de mucosa irregular con lesiones nodulares en bronquio principal derecho que se extiende a bronquio intermediario, toma de criobiopsias de bronquio intermediario y lavado bronquioalveolar de lóbulo inferior derecho, con reporte de Grocott y ácido peryódico de Schiff positivos, compatible con Cryptococcus sp., sin presencia de células malignas, GeneXpert negativo. Se realizó panendoscopia con compresión extrínseca de esófago medio, estómago retencionista y gastropatía erosiva, siendo negativo para microorganismos y células neoplásicas en la histopatología. Se hospitalizó para continuar abordaje e iniciar tratamiento antifúngico. En la exploración física sin alteraciones neurológicas, tórax con ruidos respiratorios disminuidos en región subescapular derecha; hemograma, azoados, hemoglobina glicada en rangos normales; sin transaminasemia ni hiperbilirrubinemia, marcadores inflamatorios negativos, serología para virus de la inmunodeficiencia humana (VIH), virus de la hepatitis B (VHB) y virus de la hepatitis C (VHC) no reactivos.
En hospitalización se realizó estudio tomográfico de encéfalo, pero no se encontraron alteraciones; se realizó punción lumbar con resultado positivo en panel de meningitis para Cryptococcus, tinta china y Grocott positivos, resultado de cultivo positivo para Cryptococcus gattii (Figura 2). A la semana de su ingreso se realizó biopsia pulmonar por cirugía videotoracoscópica (VATS) de lesión de lóbulo inferior en segmento 6 y lóbulo superior en segmento 3, resultado transoperatorio negativo para malignidad, se encontró infiltración a pericardio de lesión mediastinal, realizándose ventana pericárdica. La histopatología en los cortes de parénquima pulmonar con neumonía en varias etapas de organización sin evidencia de microorganismos, los cortes de pericardio y mediastino con estructuras esféricas de pared reforzada, con pseudohifa y halo periférico claro positiva para tinciones ácido peryódico de Schiff y Grocott, concluyendo criptococosis, tinción Ziehl-Neelsen negativo. En su evolución a los 20 días presentó nuevamente derrame pericárdico con separación de 28 mm y derrame pleural, se realizó lavado y drenaje de cavidad torácica más ventana pericárdica, tinciones, cultivo de biopsia de pericardio y líquido pericárdico negativos. Se mantuvo tratamiento con fluconazol y anfotericina B liposomal. Se planea seguimiento en la consulta externa para descartar inmunodeficiencias primarias u otro factor agregado.
Discusión
El Cryptococcus es un género de levaduras encapsuladas que pertenece al filo Basidiomycota y está ampliamente distribuido en todo el mundo. Se han descrito varias formas de presentación, siendo la más frecuente la pulmonar en su forma localizada y la meníngea en su forma diseminada. La principal vía de entrada es la inhalatoria, con facilidad de diseminación por la vía hematógena con gran tropismo por el sistema nervioso central.3
La criptococosis pulmonar en un paciente inmunocompetente es poco frecuente. Sin embargo, una revisión retrospectiva en China reportó que 60% de los casos de criptococosis pulmonar fueron diagnosticados en pacientes inmunocompetentes.4 Su diseminación es aún más rara, lo cual puede llevar a complicaciones fatales, siendo su mortalidad aun mayor que aquellos con infección subyacente por VIH, lo que hace que el diagnóstico precoz sea fundamental.5 Un estudio previo reportó que 67% de las criptococosis pulmonares en pacientes inmunocompetentes se diseminaron al sistema nervioso central causando meningitis criptocócica.6
Tanto el sistema inmunológico innato como el adaptativo participan en la respuesta del huésped contra la infección por Cryptococcus. Los macrófagos alveolares fagocitan el Cryptococcus, y una respuesta inmune granulomatosa puede seguir con la formación de un nódulo subpleural o un ganglio linfático primario, siendo los nódulos pulmonares una manifestación común en el examen radiológico. El destino del Cryptococcus dentro de los macrófagos está determinado por el estado inmunológico del huésped, si se encuentra comprometido puede condicionar un aclaramiento pulmonar reducido y su posible diseminación.7 En aquellos que son inmunocompetentes, se ha descrito que quienes presentan criptococosis pulmonar tienen un defecto en su sistema inmunológico, como el polimorfismo en Dectin-2, estudiado por Hu en China.8
El reconocimiento de la enfermedad en pacientes inmunocompetentes puede resultar difícil, ya que la presentación suele ser más indolente y sutil, como el paciente que se ha presentado. Esto puede provocar un retraso en el diagnóstico e inicio del tratamiento, lo que puede causar complicaciones y el desarrollo de una enfermedad más grave. Algunos estudios han informado una mayor mortalidad en pacientes no infectados por el VIH que en pacientes infectados por el VIH.9 El inicio de una terapia antifúngica es importante para la prevención de complicaciones, que puede ser particularmente desafiante en esta población.
Conclusiones
El presente reporte documenta un caso raro de criptococosis diseminada por Cryptococcus gattii en un paciente inmunocompetente. Enfatizamos la importancia de conocer las diferentes formas de presentación, así como el diagnóstico temprano y tratamiento oportuno para disminuir el riesgo de complicaciones y secuelas.
AFILIACIONES
1Instituto Nacional de Enfermedades Respiratorias Ismael Cosío Villegas, Ciudad de México, México.Conflicto de intereses: los autores declaran no tener conflicto de intereses.
REFERENCIAS
Suwatanapongched T, Sangsatra W, Boonsarngsuk V, Watcharananan SP, Incharoen P. Clinical and radiologic manifestations of pulmonary cryptococcosis in immunocompetent patients and their outcomes after treatment. Diagn Interv Radiol. 2013;19(6):438-446. Available in: https://doi.org/10.5152/dir.2013.13049